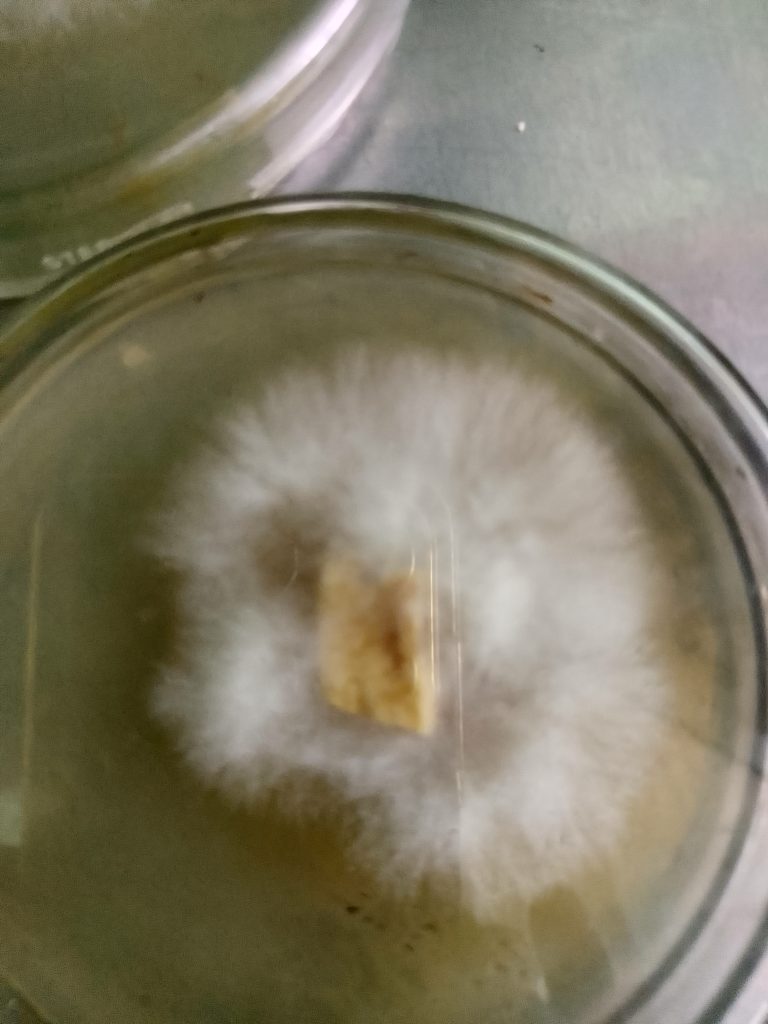
IMG_20250718_102923

Produksi Jamur Merang
Kami memproduksi jamur merang segar dengan metode pertanian yang berkelanjutan. Dengan teknologi terbaru, jamur yang dihasilkan selalu dalam kondisi terbaik, kaya gizi, dan siap untuk memenuhi kebutuhan pasar. Kami berkomitmen menjamin kepuasan pelanggan dengan produk-produk berkualitas tinggi.

Bibit Unggul
TaJam menyediakan bibit unggul hasil kultur jaringan yang terjamin kualitasnya. Bibit ini diperoleh melalui proses yang cermat dan teknologi modern, memungkinkan petani untuk mendapatkan hasil optimal dalam budidaya jamur merang. Kami mendukung pertanian lokal dengan menawarkan bibit yang terpercaya.
Pelatihan Budidaya
Kami menawarkan program pelatihan budidaya jamur untuk semua kalangan petani. Dengan pengalaman tim yang ahli, kami memberikan pengetahuan dan praktik terbaik dalam budidaya jamur, termasuk teknik terbaru dan prinsip pertanian berkelanjutan yang akan meningkatkan hasil pertanian secara signifikan.


Konsultasi Pertanian
Tim kami siap memberikan konsultasi pertanian untuk berbagai kebutuhan. Dengan pemahaman mendalam tentang budidaya jamur, kami memberikan saran dan strategi untuk mengoptimalkan hasil dan efisiensi. Ketahui cara mengatasi tantangan dalam pertanian jamur melalui pendekatan yang ramah lingkungan.
Bergabunglah dengan Komunitas Kami Hari Ini!
Ikuti kami untuk mendapatkan informasi terbaru dan penawaran menarik dari TaJam.